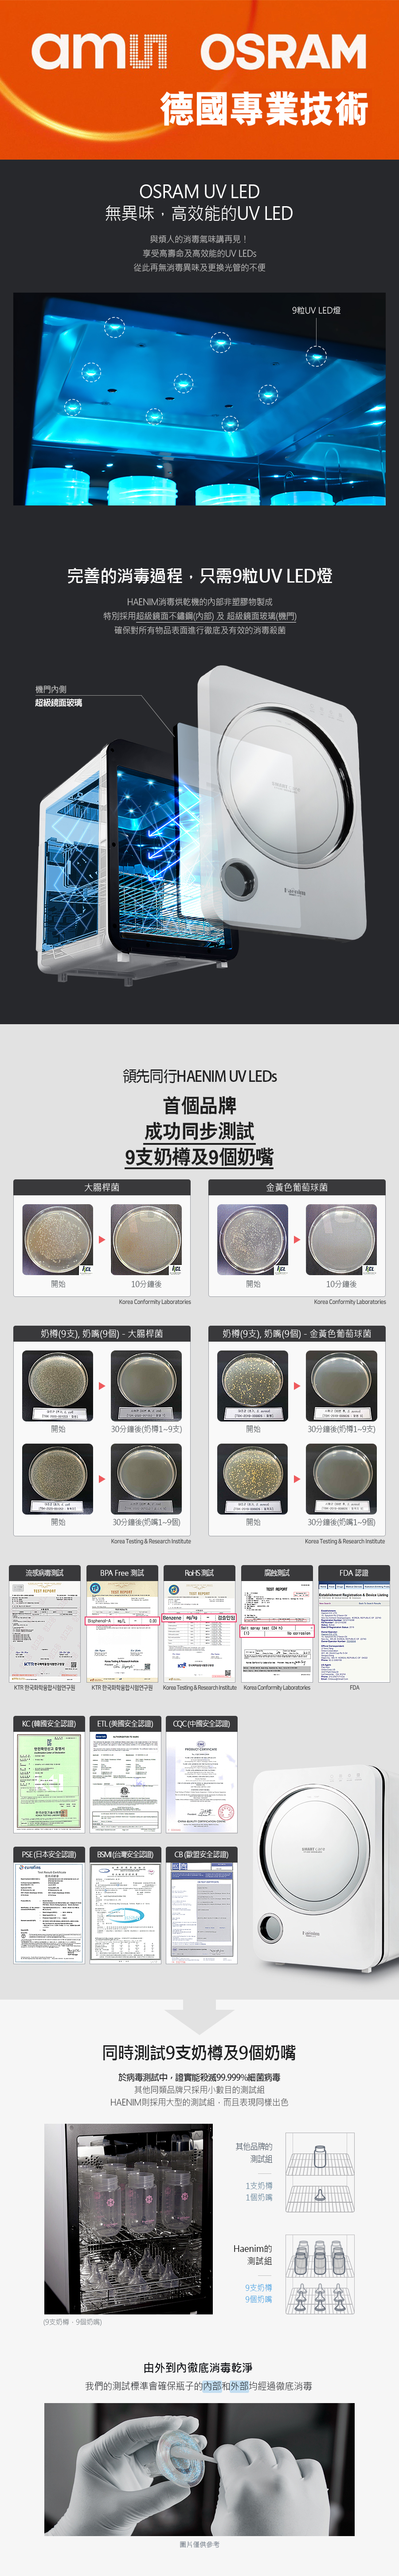

產品中文名稱
Haenim喜臨UV *LED* 消毒烘乾機 (第三代) -香港行貨
產品英文名稱
Haenim UV LED Disinfection Dryer (3rd Generation)
品牌
Haenim
品牌來自
原產地
韓國
產品說明
迎接家庭衛生的新時代,Haenim喜臨UV LED消毒烘乾機(第三代)專為現代家庭精心打造,成為您高效消毒的最佳夥伴。這款尖端烘乾機融合了創新的UV LED技術,能有效消滅99.999%的細菌與病毒,為您的家人創造一個最安全的生活空間。
優點
先進的UV LED技術:
這項技術具備高效能殺菌的能力,能夠確保每一件物品都能夠潔淨如新,徹底消除細菌和病毒,讓您在使用物品時更加安心。這不僅適用於家庭環境,也非常適合商業場合,為各種場合提供了可靠的衛生保障。
24小時無菌儲存模式:
該模式能夠持久保持物品的衛生,無論是餐具、玩具還是其他日常用品,都能隨時保持在最佳狀態,隨時準備就緒供您使用。這樣的設計讓您不必擔心細菌滋生,隨時都可以安心取用。
加速模式:
針對忙碌的家庭設計,這個模式可以快速進行消毒與烘乾,大幅度節省您的寶貴時間。在繁忙的生活中,能夠迅速完成消毒程序,使得您可以更有效率地安排日常生活,而不必再花費過多時間在清潔上。
運作時間顯示:
此功能讓您可以實時監控整個消毒過程,隨時掌握進度,使您在使用過程中感到安心無憂。無論是在家中還是辦公室,都能隨時查看設備的運作狀態,確保一切運行正常。
韓國製造:
產品採用韓國製造標準,品質有保障,不僅符合國際標準,更是經過嚴格檢測,以確保每一台設備都能夠達到最高品質要求。選擇我們的產品,讓您對品質更有信心,也為您的健康護航。
為什麼選擇Haenim喜臨?
選擇Haenim喜臨UV消毒烘乾機,讓細菌徹底失業,尤其對於有小孩的家庭和注重健康的朋友來說,這可是必備良品!
它不僅是提升生活品質的小幫手,更是您日常消毒和特殊時期健康防護的超級英雄,讓您安心無憂,生活更添樂趣!